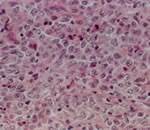

лимфома крови
Вопросы и ответы по: лимфома крови
23.10 анализ крови был в норме, только гемоглобин 143 и эозинофилы 10 %.
Начитавшись разной инфо в интернете, закрадываются самые черные мысли, про лимфому, лимфогранулематоз. Подскажите к кому идти, какие обследования еще нужно пройти, чтобы выяснить что это?
23.10 анализ крови был в норме, только гемоглобин 143 и эозинофилы 10 %.
Начитавшись разной инфо в интернете, закрадываются самые черные мысли, про лимфому, лимфогранулематоз. Подскажите к кому идти, какие обследования еще нужно пройти, чтобы выяснить что это?
Лимфома и инфекционные заболевания несколько разные понятия и патологии. Для исключения герпесвирусных инфекций можете обратиться, не вопрос, лимфома - к онкологам. Сами понимаете, по Вашей информации дать заключение просто не реально.
С уважением, Ю. Сухов.
В ноябре 2013 года у меня был тромбоз сурральных вен правой конечности, пролечили. На фоне варфарина в декабре был повторный тромбоз сурральных вен правой конечности, добавился тромбоз поверхностных. В конце декабря 2013 года на УЗИ выявили увеличенные лимфатические узлы под правой коленкой. После лечения тромбоза сохраняется скованность в коленном суставе. Остальные лимфатические узлы при осмотре не пальпируются, самочувствие и анализы крови хорошие.
По мрт в подколенной ямке визуaлизируются четыре округлrых образования мягкотканой плотности
рзмерами 3,5х2,85х2,86см, 2,74х1,76х1,9Зсм, 1,4х1,3х1,0см, 2,8х2,57хЗ,3см. структура
образований однородная, стенки достаточно четкие, небольшой отек тканей вокруг образований.
Сосудистый пучек в подколенной ямке несколько оттеснен.
Сейчас врачи настаивают на выполнение биопсии подколенного лимфатического узла, гистологии и ИГХ для определения дальнейшей тактики лечения.
Меня беспокоит расположение, опасаюсь лимфостаза или других последствий биопсии. Насколько велика возможность осложнений после биопсии подколенного узла? За 3 недели динамики в состоянии нет. Гематологи говорят, что очень странная локализация, очень нетипичная, не похожа на лимфому. Принимаю ксаредто по 1 таб. сохраняется скованность в коленном суставе и небольшая отечность коленки. Может ли тромбоз привести к росту лимфатических узлов или наоборот тромбоз следствие лимфомы? Могут ли быть другие объяснения увеличенных лимфатических узлов и тромбозов, кроме моего основного заболевания?
Спасибо.
С уважением.
Мне 29 лет, год назад у меня первичную медиастинальную В-крупноклеточную лимфому, было проведено 6 курсов высокодозной химиотерапии, в следствии чего сейчас пострадали все слизистые, в том числе кишечник и образовались трещины заднего прохода. Прошло полгода после лечения, но трещины до сих пор меня беспокоят. Кровь при опорожнении, спасаюсь ледокаином спреем. Но это не лечение. облепиховые свечи уже не помогают. Пожалуйста посовейтуйте чем могу вылечить трещины? Врач в местной больнице выписал митилурацил, но в противопоказаниях есть лимфогранулематоз. Подскажите способы и средства лечения, которые можно использовать в моем случае, т.е.чтобы не стимулировать иммунитет, не задействовать систему крови и т.д. Меня конкретно интересуют мази, свечи, ванночки, использование салкосерила...Благодарю вас за внимание!
1) Диета - питайтесь таким образом что-бы у Вас был мягкий и регулярный стул.
2) Если диеты недостаточно для нормализации стула, то принимайте слабительные. Например можно использовать такие слабительные "Мукофальк" по 1п 3 раза в день + вазелиновое масло по 1ст ложке 3 раза в день. Эти слабительные безопасные, их можно принимать длительно.
3) Для облегчения акта дефекации пользуйтесь встречной микроклизмой - при возникновении позыва на опорожнение вводите микроклизму (100мл подсолнечного масла + 100мл воды), после введения клизмы через 5-10 минут пробуйте оправляться.
4) После стула подмывайтесь теплой водой и принимайте сидячую ванночку с отварами трав (кора дуба+ромашка), сидеть 10-15 минут, температура воды 24-26С.
5) Мазь "Постеризан-форте" 2-3 раза в день,вводить 7 дней, далее мазь "Постеризан" 2-3 раза в день 4 недели, далее свечи с маслом облепихи.
С уважением Ткаченко Федот Геннадьевич.
Эозинофилы -9% (N 0,5 - 5%), базофилы - 1% (0-1%), палочки - 1% (1 -6%), сегменты - 30% (47 - 72%), моноциты - 5% ( 3 - 11%), лимфоциты - 44% (19 - 37%), атипичные мононуклеары - 10%.
Лейкоциты - 5,9 кл/мкл (4,0 - 6,0 кл/мкл),
лимфоциты абс.- 2,6 кл/мкл (0,8 - 3,6 кл/мкл),
лимфоциты % - 44% (20- 40%),
СД3 % - 65% (50 -80%),
СД3 абс - 1,69 (0,72 - 2,0),
СД4 % -34% (33 - 46%),
СД4 абс - 0,88 (0,52 - 1,15),
СД8 % - 29% (17- 30%),
СД8 абс - 0,75 (0,27 - 0,76),
СД4/СД8 - 1,17 (1,1 - 1,94),
СД16 % - 15% (12 - 23%),
СД16 абс - 0,39 (0,21 - 0,45),
СД22 % - 19% (17 - 31%),
СД22 абс - 0,49 (0,22 - 0,3),
Ауто-ток. % - 3% (0 - 5%), абс. - 0,08 (0,04 - 0,1),
фаг. активность - 61% (60 - 80%),
нейтрофилы Ф.Ч. - 4,0 (4 - 8), П.З.Ф. - 40% (>50%),
ЦИК средние - 20 (до 50), малые - 70 (до 200).
Иммуноглобулины A, M, G - норма.
Титр гетерофильных антител - 1:16 (1:8 - 1:32).
Заключение:
Атипич.мононуклеары 10%. СД22 - абс. повышение. ПЗФ - снижение.
Обследование на ВЭБ: ПЦР слюны - отрицат, кровь - Ig G ВЭБ NA - 112,8 (N до 5,0),Ig G ВЭБ ЕА - отрицат, Ig М ВЭБ VCA - отрицат.
Кровь на
ЦМВ - Ig M - 0,1 (N <0,9), Ig G - 0,5 (N <0,8);
ВПГ - Ig M - 0,1 (N <0,9), Ig G - 4,0 (N <0,9);
токсоплазма-Ig M - 0,2 (N <0,9), Ig G - 348,2 (N <20).
В анамнезе 4 года назад химиотерапия по поводу В-клеточной пролимфоцитарной лимфомы. На момент сдачи анализов данных за рецидив лимфомы гематолог не обнаружил.
Спасибо.
Дело в том, что повышение количества эозинофилов, встречатся ччаще всего при аллергических реакциях, паразитарных инвазиях, некоторых кожных заболеваниях и заболеваниях и заболеваниях крови, в том числе и при лимфомах.
С изменениями других показателей, примерно такая же картина. Хоть эти изменения более характерны для вирусной инфекции, в частности наличие атипичных мононуклеаров патогномонично для ВЭБ инфекции, однако т.к. маркеры активной ВЭБ инфекции ( антитела Ig G ВЭБ ЕА, Ig М ВЭБ VCA) отрицательны, есть вероятность, что данные изменения все же связаны с лимфомой. Правда, нельзя также исключить вероятность очень ранней ВЭБинфекции, когда данные антитела еще не образовались, для подтверждения которой необходимо было сделать ПЦР крови для выявления ДНК ВЭБ.
Так что у вас не случай для заочного консультирования, необходимо разбираться на очном приеме.
Популярные статьи на тему: лимфома крови

Лимфома крови – это не одна самостоятельная болезнь, а целая группа заболеваний, которые отличаются между собой в некоторых особенностях протекания и вместе с тем объединены одним общим признаком.

Неходжкинские лимфомы остаются одной из наиболее сложных проблем современной онкологии. Ежегодно уровень заболеваемости повышается на 2-3% и за последние 20 лет увеличился практически вдвое.

Кровь на онкологию сдают как при подозрении на наличие опухоли или онкогематологического заболевания, так и в ходе лечения таких болезней для контроля состояния больных.

Лимфома Ходжкина – злокачественная опухоль из атипичных лимфатических клеток, названная в честь первооткрывателя Томаса Ходжкина. Является одним из клеточных вариантов лимфогранулематоза. Остальные виды лимфогранулематоза называют неходжинскими лимфомами.

С развитием нового направления в медицине – заместительной регенеративно-пластической терапии – появилась возможность применения новых технологий в лечении ряда тяжелых и ранее считавшихся неизлечимыми заболеваний различного генеза.

ГГ является одной из самих распространенных вирусных инфекций человека. Свыше 90% населения земного шара инфицировано ВПГ, и до 20% из них имеют те или иные клинические проявления инфекции. Герпетические инфекции представляют собой группу...

Саркоидоз – системный, относительно доброкачественный гранулематоз неизвестной этиологии, характеризующийся скоплением активированных Т-лимфоцитов (CD4+) и мононуклеарных фагоцитов.

Идиопатический фиброзирующий альвеолит – это заболевание легких неясной природы с морфологической картиной обычной интерстициальной пневмонии, характеризующееся нарастающей легочной недостаточностью.

Вирус иммунодефицита человека (ВИЧ) является наиболее сильным из всех известных факторов риска, способствующих активации латентной туберкулезной инфекции.
Новости на тему: лимфома крови

Одним из внепеченочных проявлений вирусного гепатита С может быть синдром Шегрена, заболевание аутоиммунного происхождения, которое в свою очередь повышает риск развития опухолей лимфатической системы и онкологических заболеваний крови.

Хорошо известные и более 20 лет применяемые для лечения депрессий препараты Прозак и Анафранил, как выяснили британские медики, обладают и выраженной противоопухолевой активностью. Высокую активность оба антидепрессанта проявили против таких заболеваний как лейкемия и лимфома. Кроме того, применение препаратов-антидепрессантов усиливает действие специальных лекарств, предназначенных для борьбы со злокачественными опухолями.

Лечение рака «радиоактивными пулями» даёт новую надежду неизлечимым больным лимфомой Ходжкина. Две трети больных после эксперимента положительно отреагировали на лечение с помощью этого метода. Новая терапия называется CHT25 и использует радиоактивные изотопы, которые вводятся в поражённое место и выборочно борются с клетками лимфомы.

Вирус, который в природе поражает только кроликов, может стать орудием в борьбе человека с раком. Ученые из Университета Флориды выяснили, что вирус миксомы способен убивать раковые клетки в костном мозге человека, не задевая при этом здоровые стволовые клетки крови.
Согласно результатам нового исследования, частота лимфомы из клеток зоны мантии (одного из наиболее агрессивных типов лимфом) увеличивается, чаще поражая представителей мужского пола. Результаты исследования также показали, что обычно данное заболевание диагностируется в запущенной стадии

Согласно результатам нового исследования, использование краски для волос увеличивает риск развития определенных типов неходжкинских лимфом (рака крови с вовлечением лимфатических узлов)

Лимфомы занимают пятое место в США среди онкопатологии и насчитывают около 40 различных заболеваний, которые поражают лимфатическую систему. Лимфома – это онкологическое заболевание, субстратом которого является лимфоцит (разновидность лейкоцитов). Все виды лимфом при лечении рассматривают как хронические заболевания. Не существует единого метода лечения, эффективного для всех лимфом. Каждый вид лимфомы требует особого индивидуального подхода

Практически в каждом доме имеется небольшой арсенал средств для борьбы с всевозможным насекомыми – от докучливых комаров до тихой, но прожорливой моли. Однако воздействие таких препаратов на детский организм может привести к знакомству с онкологом…

Обычно медики не рекомендуют женщинам медлить с зачатием ребенка, так как после 30 лет возрастает риск рождения малыша с аномалиями развития. Но оказалось, что эти рекомендации могут быть адресованы и мужчинам – и повод для этого весьма серьезен…






